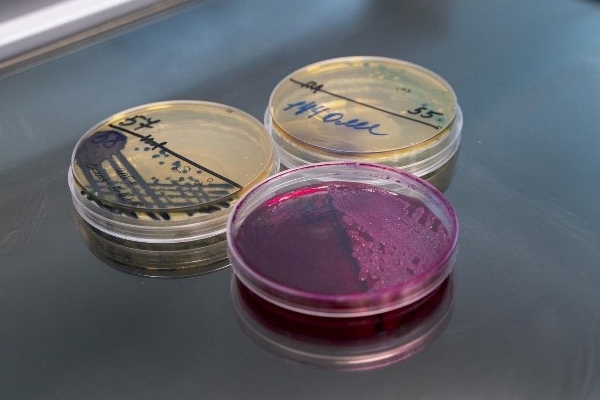
База данных онкологических пациентов с учетом региональных особенностей (Индия)

Сегодня методы лечения рака в Индии основаны на западных наборах данных, однако на молекулярном уровне рак у индийских пациентов может значительно отличаться. Отмечается потребность в более эффективных, персонализированных методах лечения, особенно с учетом уникальных генетических особенностей в и факторов окружающей среды в Индии.
В 2023 году в Индии было зарегистрировано более двух миллионов новых случаев рака – третий в мире показатель. Эта тенденция связана с поздним выявлением и неэффективным лечением заболевания. В связи с этим два года назад Индийский совет медицинских исследований, главный орган Индии по биомедицинским исследованиям, приступил к созданию наборов данных, отражающих региональные особенности Индии. Новые наборы данных, в частности, будут способствовать развитию и интеграции технологий искусственного интеллекта в здравоохранение.
В рамках государственного и частного партнерства была создана первая в стране комплексная база мультиомных данных в онкологии. В Индийском атласе генома рака (Indian Cancer Genome Atlas, ICGA) представлены данные исследований рака, характерного для индийского населения, которые могут использоваться для создания наборов данных, необходимых для разработки индивидуальных протоколов лечения.
Портал ICGA находится в открытом доступе для мирового исследовательского сообщества в соответствии с руководящими принципами Индии, которые поощряют этический обмен и сотрудничество в области исследования рака. Представленные данные содержат аннотированные последовательности ДНК и РНК и лабораторные показатели белков у пациентов с раком молочной железы, а также протоколы лечения и клинические исходы.
Фото: НИИОЗММ.
Источник: 30 сентября 2024, https://www.healthcareitnews.com/news/asia/india-specific-big-cancer-database-goes-live